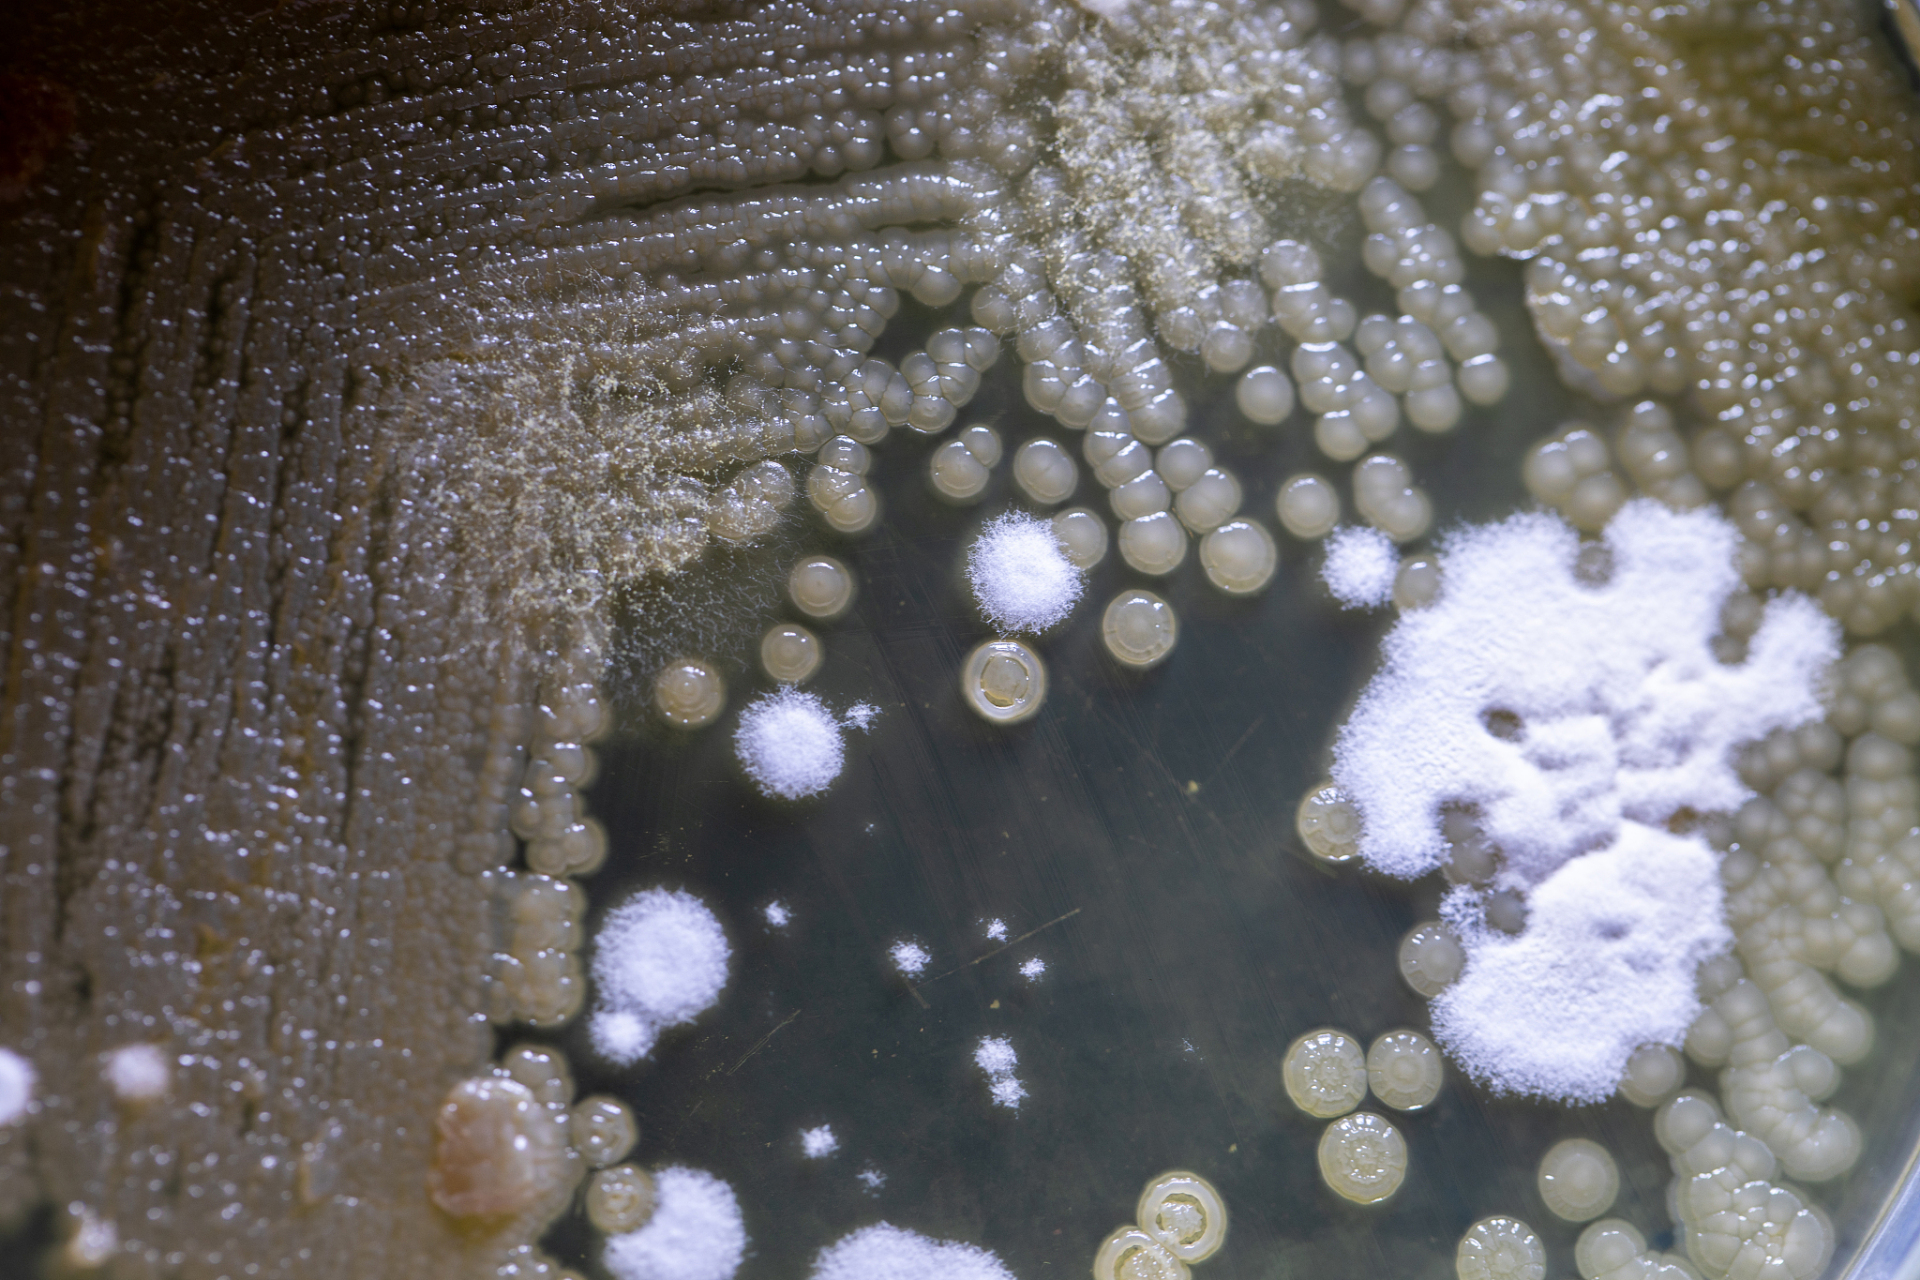
你知道抠鼻子会真菌性鼻窦炎吗?

鼻子里的细菌

鼻涕里的细菌
图片尺寸500x375
鼻子里的细菌,扫描电镜图片下载
图片尺寸800x598
研究_鼻子_细菌
图片尺寸1419x798
鼻涕里的细菌
图片尺寸640x640
动画:鼻子里的细菌
图片尺寸864x486
身上有异味,竟是鼻子惹的祸!过敏性鼻炎,鼻窦炎,哮喘…当心这些疾病
图片尺寸1080x989
日常注意这8点,还你鼻腔健康_症状_治疗_细菌
图片尺寸640x480
【围观】咳到出血,原来是鼻子出问题了
图片尺寸1077x811
火疖子 #细菌感染 #医学科普 #神评即是标题 #百万视友赐神评
图片尺寸1080x1920
鼻子细菌
图片尺寸260x321
杭州女子的鼻子居然"发霉"了!霉菌和乒乓球一样大,还具侵蚀性!
图片尺寸500x277
学习绘画和综合材料表现不同造型的细菌. 2.
图片尺寸960x1280
防不胜防的寄生虫---鼻子: 你可能会好奇,为什么你的鼻孔里面会有细菌
图片尺寸1913x1280
有人鼻子里面竟然"发霉"了?专家提醒:严重的可能要命!
图片尺寸900x600
以下是导致黄色鼻涕的几种常见原因: 感染性疾病 细菌
图片尺寸750x1000
你知道抠鼻子会真菌性鼻窦炎吗?
图片尺寸1920x1280
鼻前庭炎是一种局部细菌感染,可能由拔鼻毛,抠鼻屎等习惯带来的创伤
图片尺寸1080x806
提醒:爱挖鼻孔的人,或早或晚要承受4个后果,劝你手下留情
图片尺寸600x345
可爱的带有细菌的悲伤鼻子.向量
图片尺寸1100x1100
挖鼻孔后要洗手,避免细菌传播
图片尺寸720x960